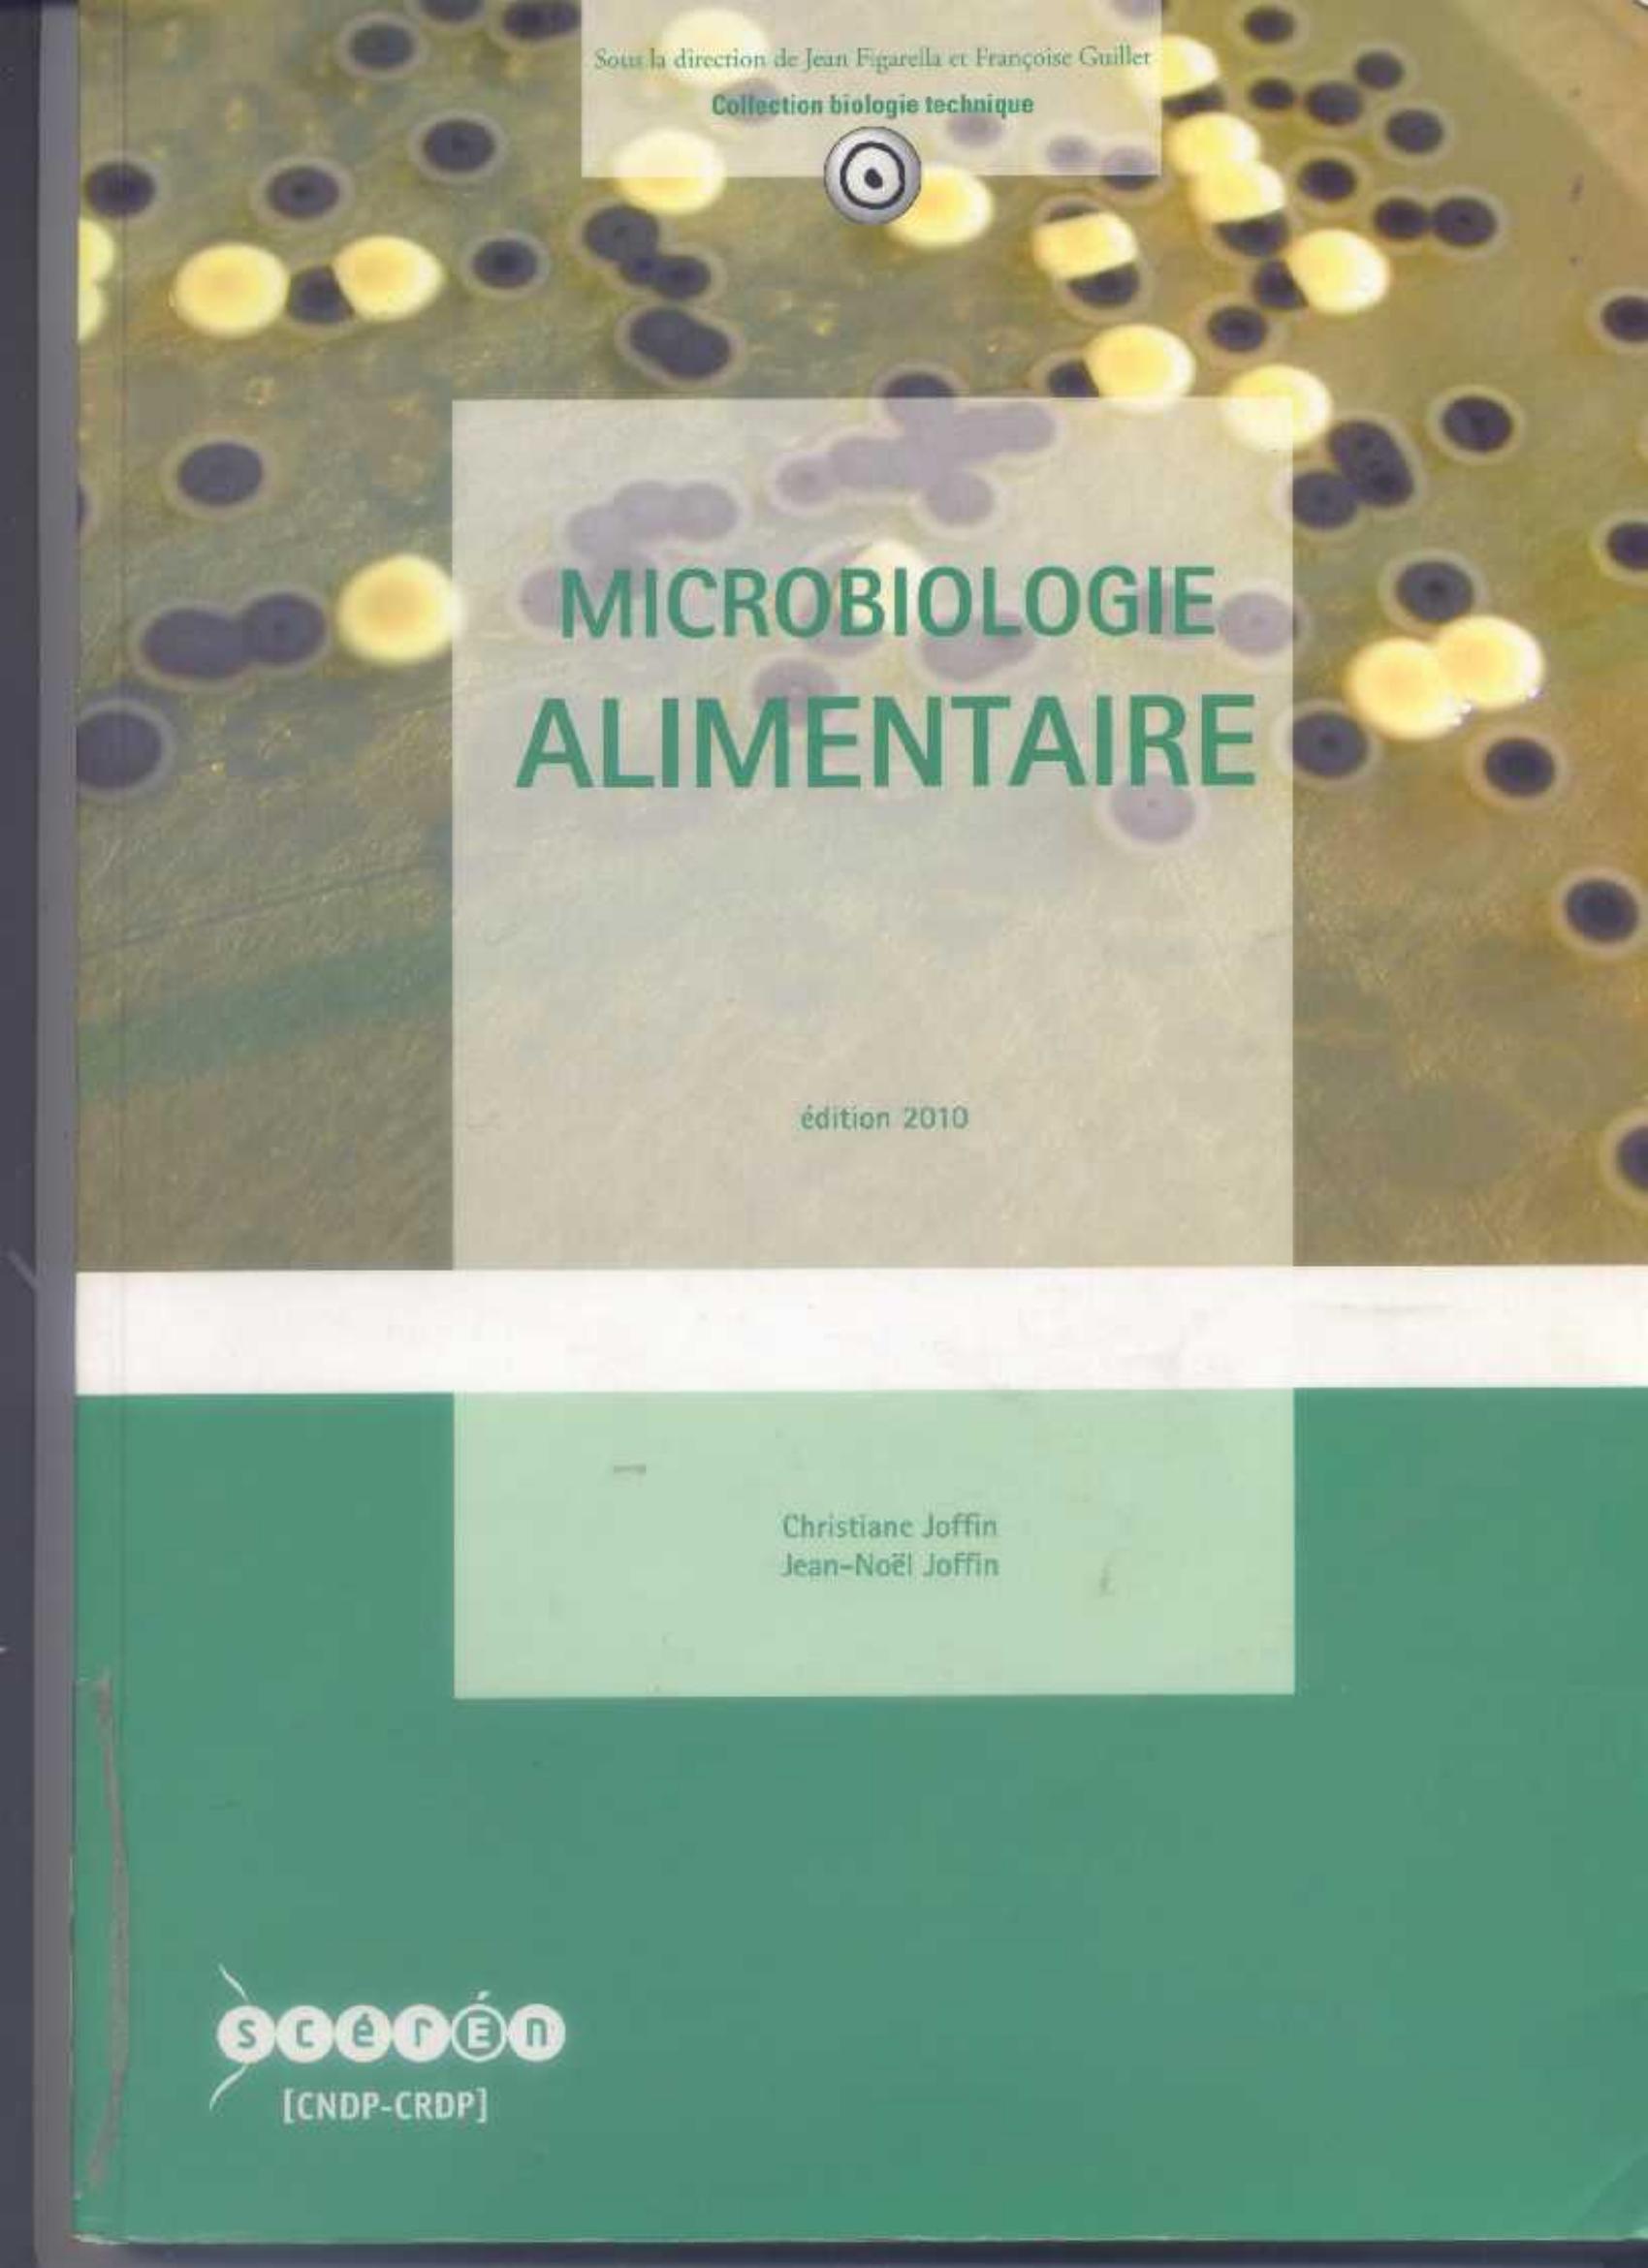

Microbiologie alimentaire
Type doc. :
Livre
Langue :
Français
Auteur(s) :
Edition :
5è éd.
Editeur(s) :
Année d'édition :
1999
ISBN :
2866173422
Afficher le Résumé
Au sommaire : la flore microbienne des aliments, origine et rôle ; les intoxications alimentaires d'origine microbienne ; les principes de l'analyse microbiologique des aliments et leur application aux diverses catégories de denrées alimentaires. Avec fiches sur les techniques, exercices et corrigés.
| N° Bulletin | Date / Année de parution | Titre N° Spécial | Sommaire |
|---|
| N° d'Exemplaire / inventaire | Cote | Localisation | Type de Support | Type de Prêt | Statut | Date de Restitution Prévue | Réservation |
|---|---|---|---|---|---|---|---|
| 048632 | BL251 | BIB-TIZI OUZOU / Mag du 3ème | Papier | externe | disponible | ||
| 048633 | BL251 | BIB-TIZI OUZOU / Mag du 3ème | Papier | externe | disponible | ||
| 056636 | BL251 | BIB-TIZI OUZOU / Mag du 3ème | Papier | externe | disponible | ||
| 056637 | BL251 | BIB-TIZI OUZOU / Mag du 3ème | Papier | externe | disponible | ||
| 056638 | BL251 | BIB-TIZI OUZOU / Mag du 3ème | Papier | externe | disponible | ||
| 056639 | BL251 | BIB-TIZI OUZOU / Mag du 3ème | Papier | externe | disponible | ||
| 056640 | BL251 | BIB-TIZI OUZOU / Mag du 3ème | Papier | externe | disponible | ||
| 24114 | BL251 | BIB-TIZI OUZOU / Mag du 3ème | Papier | externe | disponible | ||
| 048631 | BL251 | BIB-TIZI OUZOU / Mag du 3ème | Papier | externe | disponible |
Joffin, C. & Joffin, J. (1999). Microbiologie alimentaire (5è éd.) . CRDP d'Aquitaine;